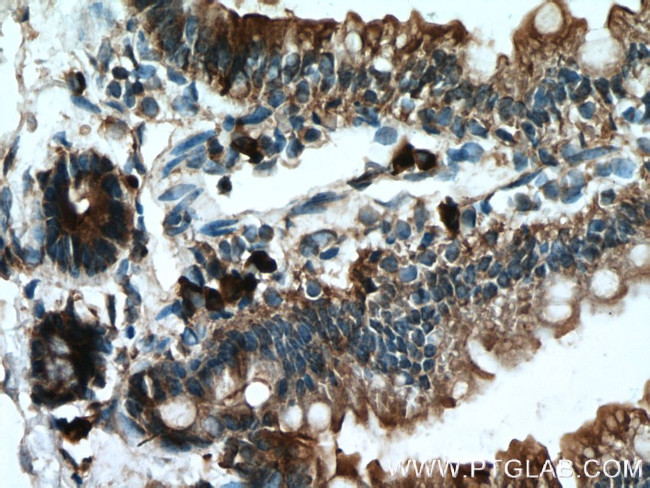
DFNA5 Antibody in Immunohistochemistry (Paraffin) (IHC (P))

Search
Proteintech
DFNA5 Polyclonal Antibody
{{$productOrderCtrl.translations['antibody.pdp.commerceCard.promotion.promotions']}}
{{$productOrderCtrl.translations['antibody.pdp.commerceCard.promotion.viewpromo']}}
{{$productOrderCtrl.translations['antibody.pdp.commerceCard.promotion.promocode']}}: {{promo.promoCode}} {{promo.promoTitle}} {{promo.promoDescription}}. {{$productOrderCtrl.translations['antibody.pdp.commerceCard.promotion.learnmore']}}
产品信息
13075-1-AP
种属反应
已发表种属
宿主/亚型
分类
类型
抗原
偶联物
形式
浓度
规格
纯化类型
保存液
内含物
保存条件
运输条件
产品详细信息
Immunogen sequence: SQSSFGTLR KQEVDLQQLI RDSAERTINL RNPVLQQVLE GRNEVLCVLT QKITTMQKCV ISEHMQVEEK CGGIVGIQTK TVQVSATEDG NVTKDSNVVL EIPAATTIAY GVIELYVKLD GQFEFCLLRG KQGGFENKKR IDSVYLDPLV FREFAFIDMP DAAHGISSQD GPLSVLKQAT LLLERNFHPF AELPEPQQTA LSDIFQAVLF DDELLMVLEP VCDDLVSGLS PTVAVLGELK PRQQQDLVAF LQLVGCSLQG GCPGPEDAGS KQLFMTAYFL VSALAEMPDS AAALLGTCCK LQIIPTLCHL LRALSDDGVS DLEDPTLTPL KDTERFGIVQ RLFASADISL (111-460 aa encoded by BC019689)
靶标信息
GSDME (Gasdermin E) is a member of the gasdermin family of pore-forming proteins that regulate programmed cell death and inflammatory signaling. Encoded by the GSDME gene, the full-length protein contains an N-terminal pore-forming domain and a C-terminal autoinhibitory domain. Under apoptotic conditions, activation of caspase-3 leads to proteolytic cleavage of GSDME, releasing the N-terminal fragment, which oligomerizes and inserts into the plasma membrane to form pores. This process can convert non-lytic apoptosis into a lytic, inflammatory form of cell death resembling pyroptosis, resulting in membrane rupture and release of intracellular contents. GSDME has been implicated in cancer biology, chemotherapy response, and tissue injury, and was originally identified in association with autosomal dominant hearing loss (historically referred to as DFNA5). Detection of cleaved GSDME is commonly used as a marker of caspase-3-mediated pore formation and inflammatory cell death.
仅用于科研。不用于诊断过程。未经明确授权不得转售。
生物信息学
蛋白别名: deafness, autosomal dominant 5 homolog; DFNA5; DFNA5, deafness associated tumor suppressor; expression inversely correlated with estrogen receptor expression in breast cancer; Gasdermin E; Gasdermin-E; ICERE-1; Inversely correlated with estrogen receptor expression 1; Non-syndromic hearing impairment protein 5; Non-syndromic hearing impairment protein 5 homolog; nonsyndromic hearing impairment protein; unnamed protein product
基因别名: 2310037D07Rik; 4932441K13Rik; DFNA5; Dfna5h; EG14210; Fin15; GSDME; ICERE-1; ICERE1
UniProt ID: (Mouse) Q9Z2D3, (Human) O60443
Entrez Gene ID: (Mouse) 54722, (Human) 1687